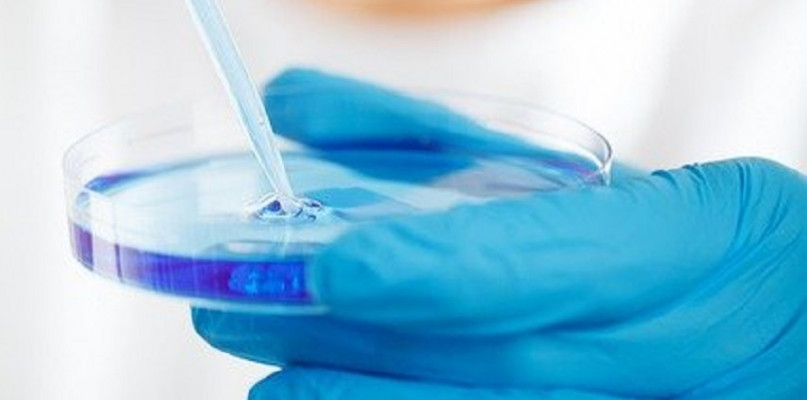

Chirurg plastyczny jest bardzo drogi, szczególnie jeśli mamy do poprawy kilka miejsc. Lepszym sposobem będzie zapoznanie się z innymi niechirurgicznymi zabiegami, w klinice Medycyna estetyczna Olsztyn jest mnóstwo zabiegów dla każdego.
Medycyna estetyczna to dziedzina medycyny, która skupia się na poprawie wyglądu i samooceny pacjenta. Obejmuje zapobieganie, diagnozowanie i leczenie zmian skórnych związanych z wiekiem, trądziku, wypadania włosów, zmarszczek i innych zmian fizycznych. Jest również znana jako medycyna kosmetyczna, chirurgia plastyczna lub dermatologia. Stała się jedną z najszybciej rozwijających się specjalności medycznych ostatnich lat, ponieważ zajmuje się poprawą zarówno fizycznych, jak i psychologicznych aspektów życia człowieka.
Istnieje wiele różnych rodzajów zabiegów estetycznych, które można wykonać, aby poprawić wygląd osoby. Obejmują one:
Zastrzyki z botoksu
Skórki chemiczne
Laserowe usuwanie włosów
Wypełniacze do twarzy
Powiększanie ust
Świat medycyny estetycznej się zmienia. Tradycyjne metody medycyny estetycznej są obecnie uzupełniane o nowe i ulepszone technologie. Medycyna Estetyczna Olsztyn to jedna z najlepszych klinik w Polsce zajmująca się leczeniem problemów skórnych, trądziku, przebarwień, blizn i zmarszczek. Oferują szeroką gamę zabiegów, które mogą pomóc Ci wrócić do najlepszej formy. W klinice pracują jedni z najbardziej doświadczonych lekarzy w tej dziedzinie, którzy pomogli tysiącom osób osiągnąć upragniony wygląd.
Medycyna estetyczna Olsztyn to nowa i innowacyjna usługa medyczna w Polsce. To multidyscyplinarna klinika z najwyższym poziomem specjalistów i sprzętu. Klinika oferuje wszelkiego rodzaju zabiegi, od najczęstszych zabiegów kosmetycznych po najnowsze technologie.
Oto niektóre z zabiegów, które oferuje olsztyńska medycyna estetyczna:
- Zastrzyki z botoksu redukujące zmarszczki
- Wypełniacze zwiększające objętość
- Peelingi chemiczne poprawiające strukturę skóry twarzy
- Zabiegi laserowe do usuwania tatuaży, zmian barwnikowych i zmian naczyniowych
Medycyna estetyczna w Olsztynie zajmuje się różnego rodzaju zabiegami poprawiającymi wygląd. Może być stosowany w leczeniu problemów skórnych, takich jak trądzik, blizny i zmarszczki. Może być również stosowany przy wypadaniu lub przerzedzaniu włosów. Zabiegi medycyny estetycznej w Olsztynie nie ograniczają się tylko do problemów z urodą, ale obejmują również inne zagadnienia, takie jak odchudzanie i pielęgnacja zębów.
Liposukcja to zabieg chirurgiczny, który usuwa tłuszcz z organizmu. W przeciwieństwie do tradycyjnej liposukcji liposukcja strzykawkowa wykorzystuje cienką rurkę do usuwania tłuszczu i odbywa się przez małe nacięcia. Strzykawka ma wąski otwór i jest wkładana do ciała. Tłuszcz jest następnie wstrzykiwany przez ten otwór, gdzie można go przechowywać do późniejszego wykorzystania.
Zabieg jest powszechnie stosowany u osób, które chcą usunąć zlokalizowane złogi tłuszczu. Może być również stosowany u osób, które przeszły operację odchudzania i potrzebują dodatkowego zabiegu liposukcji. Służy głównie do usuwania tłuszczu ze zlokalizowanych obszarów, które są oporne na dietę i ćwiczenia. Wykorzystywany jest również w leczeniu otyłości oraz w celach kosmetycznych.
Technika liposukcji strzykawkowej jest ogólnie uważana za bardziej skuteczną niż tradycyjna technika liposukcji, ponieważ można ją wykonać przy mniejszym bólu, obrzęku i siniakach. Ta procedura została po raz pierwszy opracowana w 1990 roku, ale stała się popularna w 2002 roku, kiedy została zastosowana u piosenkarki Jennifer Lopez.
Liposukcja strzykawkowa Olsztyn to nie tylko usuwanie nadmiaru tłuszczu z organizmu, ale także poprawa wyglądu przy mniejszym obciążeniu twarzy i innych części ciała.
Nici liftingujące to niechirurgiczny rodzaj liftingu twarzy, który wykonuje się za pomocą nici. Jest to technika polegająca na usuwaniu włosów z twarzy i innych części ciała za pomocą skręconych nici bawełnianych. Nawlekanie można wykonać na dowolnej części ciała, ale najczęściej stosuje się je do usuwania włosów z obszarów twarzy, takich jak brwi, górna warga i podbródek. Nawlekanie może być również stosowane do modelowania brwi lub usuwania niechcianego owłosienia z twarzy.
Nici liftingujące to nowa, niechirurgiczna technika liftingu twarzy, która staje się coraz popularniejsza. Jest to dobra alternatywa dla zabiegów chirurgicznych. Są też tańsze i mniej inwazyjne. Przechodzą pod skórę i dochodzą do mięśnia, unosząc je do góry, tworząc naturalnie wyglądający lifting.
Bezoperacyjny lifting twarzy nici liftingujące Olsztyn, koniecznie odwiedź klinikę, gdy szukasz niechirurgicznego, bezbolesnego i szybkiego sposobu na odmłodzenie swojej skóry.